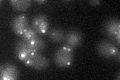
YDR329C
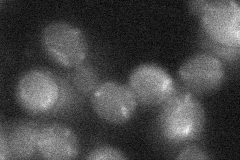
YDR329C
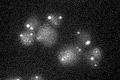
YDR329C

View description
Peroxisomal membrane protein (PMP) required for proper localization and stability of PMPs; anchors peroxisome retention factor Inp1p at the peroxisomal membrane; interacts with Pex19p
Localization:
Intensity:
Fold change:
Significance:
-
C’ GFP library in SD
punctate22.18 -
N' NOP1pr-GFP in SD

punctate59.8326 -
N' TEF2pr-mCherry in SD

punctate59.5896 -
N' NATIVEpr-GFP in SD

punctate16.7508 -
N' TEF2pr-VC and Cyto-VN in SD
below threshold25.9181 -
C’ GFP library in SD+DTT

punctate21.220.95No -
C’ GFP library in SD+H2O2

punctate21.420.96No -
C’ GFP library in Starvation Media
punctate23.691.06No -
C’ GFP library on the background of Pup2-DaMP

N/A -
C’ GFP library on the background of CCT mutant

N/A0N/AYes
